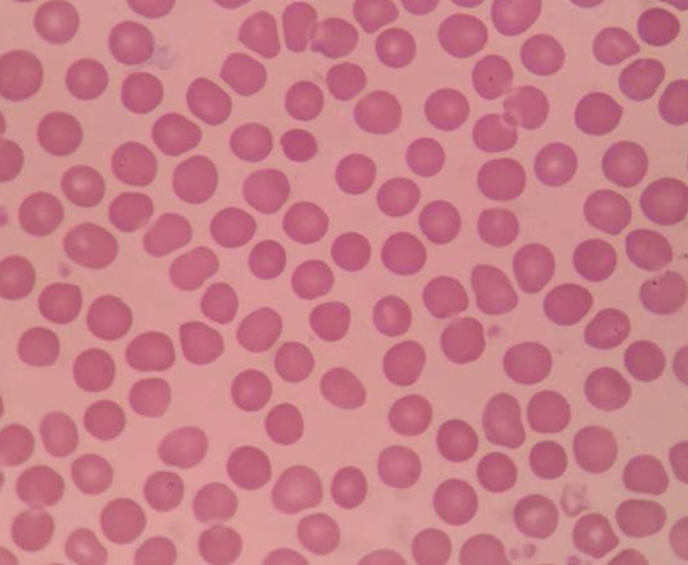

发布时间:2021-07-31
近日,广东番禺部分地区封城,很多人都不知道为什么。
6月8日,广州疫情防控新闻发布会上通报:住在番禺区大石街北联村的确诊病例祝某,隐瞒旅居史、接触史,导致大量群众成为密切接触者、次密接触者!祝某目前已被刑拘。

*提示瞒报需负刑事责任
在这场与新冠肺炎的战役中,除了医护工作者与病毒作战外,我们身体里的免疫细胞也在努力工作。
每天,有数以亿计的免疫细胞在骨髓中生成,而每个成年人体内大约有2万亿个免疫细胞,它们就像一个个战士,一直在守护着人体的健康。

白细胞就像人体里面的特种兵,战斗力十足。
它们生在骨髓,长在胸腺,在胸腺接受一段时间的“训练”。当再次走出胸腺时,它们就成了一个个可以随时出征的特种兵。

T细胞不像其他白细胞那样,只要是病毒,就不管三七二十一,一起上去群殴。T细胞只对付一种特定的病毒。人体的无数个T细胞中,通常只有一个T细胞会作出反应。这真是做到了精准打击!
树突状细胞就像一个个张牙舞爪的树妖。平时,它们就像巡逻兵一样,在身体各处转悠。一旦发现病毒,它们就会猛扑上去,迅速将其吞食,之后在体内对这个病毒进行加工,提取病毒的特征“碎片”,并联络可以对付这种病毒的T细胞。

在病毒入侵身体不久,某个特定的B细胞其实已经获得了病毒的一些信息,但它迟迟没有动手,是因为需要等T细胞过来跟它交换信息,做最后的确认。

当B细胞被T细胞激活,B细胞就会赶紧分裂自己,在短时间内复制出大量的B细胞,并不断地制造大量的“导弹”。一秒钟内,一个B细胞大约能发射2000发“导弹”,而这些导弹学名叫抗体。
自然杀伤细胞又称NK细胞,NK细胞属于白细胞的一种,它是人体忠诚的卫士,主要任务就是消灭那些已经被病毒感染的细胞,从而把病毒消灭在“摇篮”中。

另外,肿瘤细胞也是它们追杀的对象。NK细胞使用的武器就是“穿孔素”,当它把穿孔素“喷在”细胞上时,能在细胞上打一个小洞,从而消灭细胞及细胞里的病毒。

NK细胞追杀肿瘤细胞
单核细胞是血液中最大的血细胞,像孙悟空一样会变身,运动能力也很强,能从血液中离家出走,不但能吞噬病菌,还能清除受伤和衰老的细胞及其碎片。

如果身体里某个地方出现了炎症,那么,单核细胞会在8到12小时内,快速聚集到感染组织。
当单核细胞从血液中离家出走,来到身体的其他组织中时,单核细胞的体积会增大,这时它变成了一个更加强大的人体斗士——巨噬细胞!

巨噬细胞一直在为我们的身体做清洁工作,它们会吞掉那些进入肺里面的细小尘埃,我们的肺才不至于被无数的尘埃污染。
它还会吞掉那些死去的细胞,比如死去的红细胞等。如果忙不过来,巨噬细胞还会召唤其它同伴一起来战斗。作为人体的强大卫士,巨噬细胞可以吞掉大量病菌,最后死于自己分泌的消化混合物。
这个胖子是白细胞的一种,在血管外活动,是具有强嗜碱性颗粒的组织细胞,它在速发型支气管哮喘中,起着十分重要的作用。

它是哺乳动物血液中最主要的白细胞,来源于骨髓,生成很快,但只能存活两三天。它在先天性免疫系统中起着非常重要的作用。

它是白细胞中体积最小的一种,是一类具有免疫识别功能的细胞系。上文中提到的T细胞、B细胞和NK细胞,都是这个家族中的成员。

体温提升1°C,免疫力增强5~6倍,君康能阳光屋内热升温,提高人体免疫力!
医学研究表明,体温每降1°C,免疫力就会下降30%以上;体温每升高1°C,免疫力就会提高5~6倍。
君康能阳光屋萃取远红外线中5.6~15微米的阳光精华,此段精华被称为“生命光线”。是人类赖以生存和维持健康必不可少的物质。

阳光精华能渗透人体皮肤4~5cm,直接作用于深层组织,补充细胞能量。

阳光精华与人体细胞产生同频共振效应,让全60万亿个细胞活跃起来。
阳光精华的能量让身体由内而外的温热起来,促进血液循环,加快新陈代谢,细胞获得更多的氧气与营养,从而提高白细胞的工作效率,增强人体免疫力

